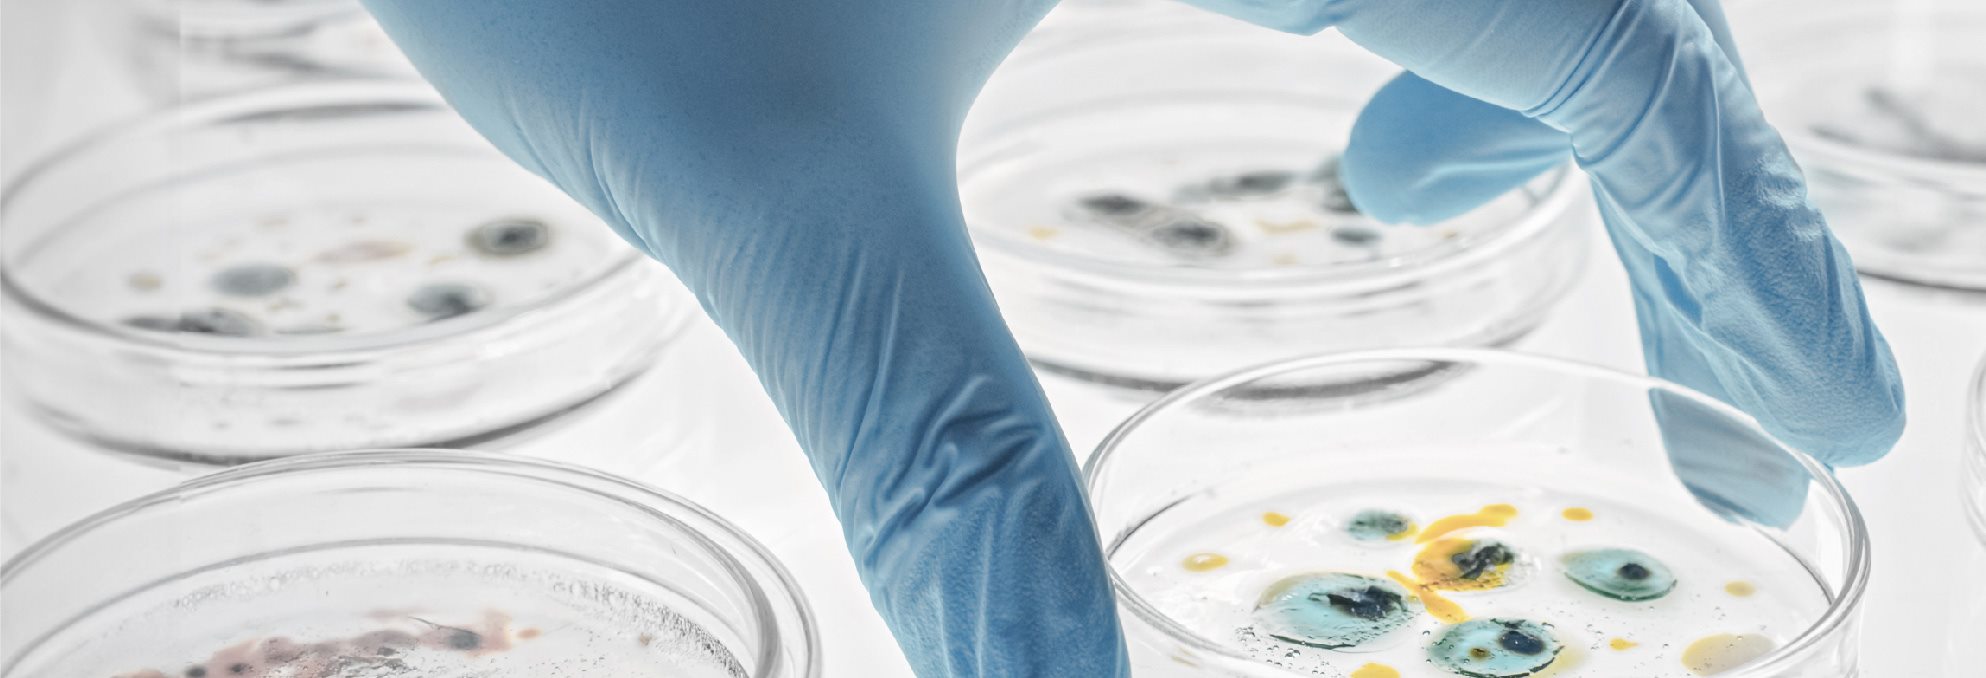

TASK
Designing the look of a fully automated microbial mass spectrometry detector with a product appearance in line with the cost-effective market positioning of clinical laboratories.
Transfer of the recognizable zybio product language
Finding variability within the corporate characteristics while maintaining coherence